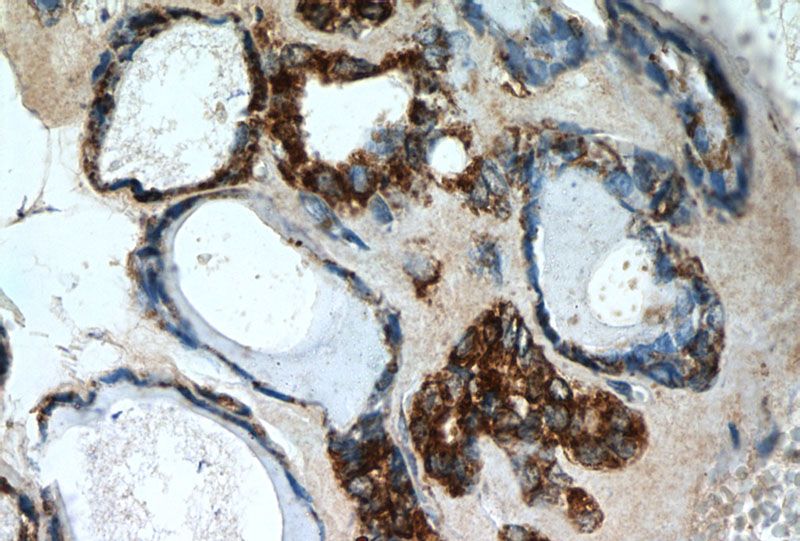
Immunohistochemistry of paraffin-embedded human thyroid tissue slide using Catalog No:108908(calreticulin Antibody) at dilution of 1:50 (under 40x lens)

-
Product Name
calreticulin antibody
- Documents
-
Description
calreticulin Rabbit Polyclonal antibody. Positive WB detected in NIH/3T3 cells, COLO 320 cells, HeLa cells, HL-60 cells, human skeletal muscle tissue, MCF7 cells, mouse brain tissue. Positive IHC detected in human thyroid tissue, human colon cancer tissue, human ovary tumor tissue, human skeletal muscle tissue. Positive IF detected in NIH/3T3 cells. Observed molecular weight by Western-blot: 60 kDa
-
Tested applications
ELISA, WB, IF, IHC
-
Species reactivity
Human, Rat, Mouse; other species not tested.
-
Alternative names
CALR antibody; Calregulin antibody; calreticulin antibody; cC1qR antibody; CRP55 antibody; CRT antibody; CRTC antibody; ERp60 antibody; FLJ26680 antibody; grp60 antibody; HACBP antibody; SSA antibody
-
Isotype
Rabbit IgG
-
Preparation
This antibody was obtained by immunization of calreticulin recombinant protein (Accession Number: NM_004343). Purification method: Antigen affinity purified.
-
Clonality
Polyclonal
-
Formulation
PBS with 0.1% sodium azide and 50% glycerol pH 7.3.
-
Storage instructions
Store at -20℃. DO NOT ALIQUOT
-
Applications
Recommended Dilution:
WB: 1:200-1:2000
IHC: 1:50-1:500
IF: 1:20-1:200
-
Validations

NIH/3T3 cells were subjected to SDS PAGE followed by western blot with Catalog No:108908(calreticulin Antibody) at dilution of 1:600

Immunohistochemistry of paraffin-embedded human thyroid tissue slide using Catalog No:108908(calreticulin Antibody) at dilution of 1:50 (under 10x lens)
Immunohistochemistry of paraffin-embedded human thyroid tissue slide using Catalog No:108908(calreticulin Antibody) at dilution of 1:50 (under 40x lens)

Immunofluorescent analysis of (-20oc Ethanol) fixed NIH/3T3 cells using Catalog No:108908(calreticulin Antibody) at dilution of 1:50 and Alexa Fluor 488-congugated AffiniPure Goat Anti-Rabbit IgG(H+L)
-
Background
CALR,also named as grp60, ERp60, HACBP, CRP55, CRTC and Calregulin, belongs to the calreticulin family. It is a molecular calcium-binding chaperone promoting folding, oligomeric assembly and quality control in the ER via the calreticulin/calnexin cycle. CALR is a ER marker. It interacts transiently with almost all of the monoglucosylated glycoproteins that are synthesized in the ER. CALR interacts with the DNA-binding domain of NR3C1 and mediates its nuclear export. The MW of CALR migrates aberrantly at 60 kD by SDS-PAGE. Some study provided that it's a new possibility for CRT-mediated tumor immune prevention and treatment.
-
References
- Yang X, Zou P, Yao J. Proteomic dissection of cell type-specific H2AX-interacting protein complex associated with hepatocellular carcinoma. Journal of proteome research. 9(3):1402-15. 2010.
- Lu CM, Wu YJ, Chen CC. Identification of low-abundance proteins via fractionation of the urine proteome with weak anion exchange chromatography. Proteome science. 9:17. 2011.
- Deisenroth C, Itahana Y, Tollini L, Jin A, Zhang Y. p53-Inducible DHRS3 is an endoplasmic reticulum protein associated with lipid droplet accumulation. The Journal of biological chemistry. 286(32):28343-56. 2011.
- Yao W, Fan W, Huang C, Zhong H, Chen X, Zhang W. Proteomic analysis for anti-atherosclerotic effect of tetrahydroxystilbene glucoside in rats. Biomedicine & pharmacotherapy = Biomédecine & pharmacothérapie. 67(2):140-5. 2013.
- Yang MS, Wang HS, Wang BS. A comparative proteomic study identified calreticulin and prohibitin up-regulated in adrenocortical carcinomas. Diagnostic pathology. 8:58. 2013.
- Cheng KC, Huang HH, Hung CT. Proteomic analysis of the differences in orbital protein expression in thyroid orbitopathy. Graefe's archive for clinical and experimental ophthalmology = Albrecht von Graefes Archiv für klinische und experimentelle Ophthalmologie. 251(12):2777-87. 2013.
Related Products / Services
Please note: All products are "FOR RESEARCH USE ONLY AND ARE NOT INTENDED FOR DIAGNOSTIC OR THERAPEUTIC USE"
